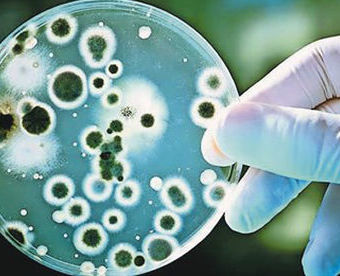
服務項目照片

營業時間
-
星期日
店休
-
星期一
08:00 - 17:00
-
星期二
08:00 - 17:00
-
星期三
08:00 - 17:00
-
星期四
08:00 - 17:00
-
星期五
08:00 - 17:00
-
星期六
08:00 - 11:40
公司資訊
Zavod za promocijo zdravja in zdrave prehrane je zasebni zavod. V Zavodu Zdravje združujemo znanje usposobljenih strokovnjakov, zdravnikov, diagnostikov in specialistov iz raznih področij: nutricizma, dietetike, medicine, psihoterapije, športa ter pri tem sodelujemo z gospodarskimi družbami, ustanovami in posamezniki.Zavod Zdravje deluje na območju celotne Slovenije, ordinacijske prostore ima v Ljubljani, Mariboru in Izoli. Razvojni poslovni model Zavoda Zdravje je franšiza, zato se za širitev in boljšo dostopnost naših storitev že dogovarjamo z zainteresiranimi zdravstvenimi strokovnjaki po slovenskih mestih. Odprti smo za nove predloge in ideje, ki bi še izboljšale naše storitve, dvignile kvaliteto življenja naših klientov ter izboljšale medčloveške odnose.Zavod Zdravje je specializiran za opravljanje preventivnih diagnostičnih storitev za individualne kliente in zaposlene v pravnih subjektih.V Zavodu Zdravje poseben pomen dajemo aktivnostim v sklopu promocije zdravja na delovnem mestu. Razvili smo učinkovit program usposabljanja promoterjev zdravja pri pravnih osebah ter izjemno uporaben progrm sistematičnih letnih preventivnih pregledov.ZAVOD ZDRAVJE, Zavod za promocijo zdravja in zdrave prehraneZaloška c. 149, 1000 Ljubljana, tel: 040 28 98 00Ordinacija LJUBLJANA, Zaloška c. 149, 1000 Ljubljana, tel: 040 28 98 00Ordinacija MARIBOR, Gosposvetska c. 41, 2000 Maribor, tel: 040 88 99 26Ordinacija IZOLA, Drevored 1. maja 4a, 6310 Izola, 1. nad.; tel: 040 88 99 32Studio MEDICO ISOLA, Viale I maggio 41, 6310 Isola, 1. piano; tel: 040 88 99 32info@zavodzdravje.si, www.zavodzdravje.si團隊組成

Zavod Zdravje - Ordinacija Ljubljana, Zaloška cesta 149, 1000 Ljubljana

Zavod Zdravje - Ordinacija Izola, Drevored 1. maja 4a, 6310 Izola

Zavod Zdravje - Ordinacija Maribor, Gosposvetska c. 41, 2000 Maribor
熱門服務

Pregled stanja srca in ožilja - ARTERIOGRAFIJA ( cena 75,00 eur )
20 分鐘
Arteriografija je neinvaziven, nenevaren in neboleč postopek pregleda ožilja. Pregled traja le nekaj minut, izmerimo vaš tlak in krivuljo pulznega vala. Ob zaključku izdamo rezultate merjenja - arteriogram z razlago in nasveti. Z meritvijo se boste p

Ultrazvočni pregled kostne gostote - DEZINTOMETRIJA
20 分鐘
Dezintometrija je neinvaziven, nenevaren in neboleč ultrazvočni postopek pregleda kostne gostote brez sevanja, bolj natančen od rentgena. Pri pregledu izmerimo oceno stanja vaši kolkov in hrbtenice. Ob zaključku izdamo rezultate. Z meritvijo se boste

Preventivni diagnostični pregled za ženske in moške
40 分鐘
Preventivni diagnostični pregled za ženske in moške je računalniško podprt, neinvaziven, nenevaren in neboleč postopek pregleda telesa brez slačenja, sevanja in stranskih učinkov. Pri pregledu preverjamo stanje 7 najpomembnejših organskih sistemov: d

Pregled za ščitnico
20 分鐘
Preventivni pregled ščitnice je računalniško podprt, neinvaziven, nenevaren in neboleč postopek pregleda brez slačenja, sevanja in stranskih učinkov. Pri pregledu preverjamo oceno stanja ščitnice (velikost, zgradbo in prekrvljenost ščitnice), zaznamo

Pregled za sečila
20 分鐘
Preventivni pregled sečil je računalniško podprt, neinvaziven, nenevaren in neboleč postopek pregleda brez slačenja, sevanja in stranskih učinkov. Pri pregledu preverjamo oceno stanja sečil, zaznamo razne tvorbe in ciste, če so prisotne in ocenimo nj

Pregled za prebavila
20 分鐘
Preventivni pregled prebavil je računalniško podprt, neinvaziven, nenevaren in neboleč postopek pregleda brez slačenja, sevanja in stranskih učinkov. Pri pregledu preverjamo oceno stanja prebavil, zaznamo razne tvorbe in ciste, če so prisotne in ocen

Pregled za bolezni kože
20 分鐘
Preventivni pregled za bolezni kože je računalniško podprt, neinvaziven, nenevaren in neboleč postopek pregleda brez slačenja, sevanja in stranskih učinkov. Pri pregledu preverjamo oceno stanja kože, zaznamo razne tvorbe in ciste, če so prisotne in o

Pregled za zakisanost organizma
20 分鐘
Preventivni pregled zakisanosti organizma je računalniško podprt, neinvaziven, nenevaren in neboleč postopek. Pregled poteka brez slačenja, sevanja in stranskih učinkov. Pri pregledu preverjamo oceno stanja organizma, zaznamo razne tvorbe in ciste, č

Pregled za HPV virus
20 分鐘
Preventivni pregled za HPV virus je računalniško podprt, neinvaziven, nenevaren in neboleč postopek. Pregled poteka brez slačenja, sevanja in stranskih učinkov. Pri pregledu preverjamo stanje oz. prisotnost HPV virusa v organizmu. Ob zaključku prejme

Pregled prostate
20 分鐘
Preventivni diagnostični pregled prostate je računalniško podprt, neinvaziven, nenevaren in neboleč postopek pregleda telesa brez slačenja, sevanja in stranskih učinkov. Ob zaključku prejmete izvid in opravite pogovor s diagnostikom, ki vam tudi razl

Pregled dojk
20 分鐘
Preventivni diagnostični pregled za ženske je računalniško podprt, neinvaziven, nenevaren in neboleč postopek pregleda telesa brez slačenja, sevanja in stranskih učinkov. Pri pregledu preverjamo stanje dojk. Ob zaključku prejmete izvid in imate pogov

Kontrolni pregled
20 分鐘
Kontrolni pregled za ženske in moške je računalniško podprt, neinvaziven, nenevaren in neboleč postopek pregleda telesa brez slačenja, sevanja in stranskih učinkov. Pri pregledu preverjamo stanje po opravljenemu pregledu in po ravnanju po navodilih d

Celostna diagnostika
90 分鐘
評論
12 客戶評論